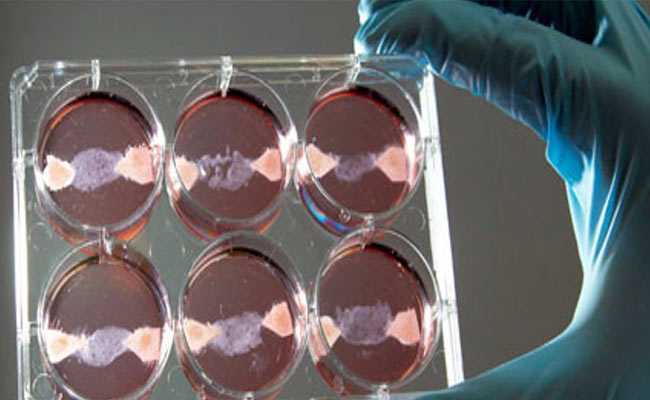
Pollo coltivato in laboratorio e carne sintetica, a che punto siamo

Pollo coltivato in laboratorio e carne sintetica, a che punto siamo
di Redazione

La ricerca di polli con carne artificiale: è l'azienda di Memphis Carni che ha annunciato oggi di aver sviluppato il pollo e carne di anatra dalle cellule in coltura di ogni uccello, producendo “animali da cortile pulito.” L'azienda ha fornito pochi dettagli, anche se i partecipanti a una degustazione hanno fornito esiti positivi. Di seguito è riportato il report di una storia originariamente pubblicato 23 agosto 2016 su alcune delle sfide regolamentari e le domande che ha affrontano la Memphis Carni e altre aziende che sviluppano carni artificiali.
Il primo hamburger cucinato con carne da laboratorio non ha ottenuto recensioni entusiastiche per il gusto . Ma l'hamburger in provetta, lanciato alla stampa nel 2013, ha contribuito a mettere sotto i riflettori la questione di come il governo degli Stati Uniti regolerà il settore emergente dell'agricoltura cellulare, che utilizza la biotecnologia invece di animali per rendere i prodotti come la carne, il latte e albume d'uovo.
Finora, nessuno di questi alimenti sintetici ha raggiunto il mercato. Ma alcune startup negli Stati Uniti e anche altrove, stanno cercando di aumentarne la produzione. Nella zona di San Francisco Bay in California, gli imprenditori della Memphis Carni sperano di avere le loro polpette di cellule in coltura, come hot dog, salsicce ecc. sugli scaffali dei negozi entro i prossimi 5 anni, e quelli delle catene Perfect Day stanno prendendo di mira la fine del 2017 per distribuire vacca prodotti lattiero-caseari cruelty free.
Storicamente, il Dipartimento dell'Agricoltura degli Stati Uniti (USDA) regola la produzione di carne, pollame, uova e, mentre la Food and Drug Administration (FDA) sorveglia la sicurezza degli additivi alimentari. FDA approva anche i cosiddetti biologici, che comprendono prodotti ottenuti da tessuti umani, sangue, cellule, e tecniche di terapia genetica. Ma le biotecnologie emergenti possono offuscare quelle linee di supervisione, perché alcuni dei nuovi alimenti che non rientrano esattamente nelle definizioni attualmente esistenti. “La cultura cellulare solleva un sacco di domande”, conferma Isha Datar, CEO di New Harvest, un'organizzazione no-profit di New York City fondata per sostenere questa industria nascente.
 Per contribuire a fornire risposte, la Casa Bianca lo scorso anno ha lanciato un'iniziativa per rivedere e revisionare come le aziende degli Stati Uniti regolano biotecnologia agricola . E la National Academies of Sciences, Ingegneria, Medicina e di Washington, DC, sta lavorando ad un più ampio studio di futuri sviluppi delle biotecnologie e regolamentazione , con un rapporto previsto in uscita alla fine di quest'anno.
Nel frattempo, i leader del settore stanno pensando a come i loro potenziali alimenti di laboratorio potrebbero essere gestii dalle autorità di regolamentazione. Un approccio, pubblicato da Science Insider, è quello di mostrare che il loro prodotto è simile a un prodotto esistente che il test ha già dimostrato di utilizzare senza pericoli. “La maggior parte delle regolamentazioni alimentari stanno allineando i nuovi prodotti con qualcosa che è già riconosciuto come sicuro”, osserva Datar.
Questo è l'approccio già adottato dalle aziende che utilizzano microbi e altre biotecnologie per la produzione di enzimi e proteine che vengono aggiunti agli alimenti, fa notare Vincent Sewalt, senior director, gestione prodotti e normative, per la DuPont Industrial Biosciences, con sede a Palo Alto, California. Ad esempio, il lievito può essere utilizzato per la produzione di amilasi specifici, che sono enzimi per prodotti da forno per prolungare la freschezza. Tali additivi richiedono l'approvazione da parte della FDA prima dell'immissione sul mercato “a meno che non si riesce a dimostrare che sono sostanze generalmente riconosciute come sicure”, dice Sewalt. Per soddisfare questi standard noti nel settore come GRAS- le aziende iniziano selezionando ceppi microbici che sono noti per essere non tossici e non patogeni, quindi utilizzando quei ceppi per produrre i loro prodotti. “E questo può essere fatto in modo sicuro fino a quando si abbia selezionato un ceppo di sicurezza e ha dimostrato che la sicurezza attraverso ripetuti studi tossicologici”, conferma Sewalt.
Questa strategia potrebbe funzionare anche per le aziende che sperimentano l'utilizzo di lieviti ingegnerizzati per produrre singole proteine per creare i bianchi d'uovo, senza screpolature. In questo caso, le proteine del bianco d'uovo sono già considerati un ingrediente GRAS.
Lo stesso scenario potrebbe anche funzionare per Perfect Day, la startup che sta usando il lievito per fare proteine del latte, e quindi l'aggiunta di altri ingredienti per creare un latte senza l'utilizzo di bovini. Quelle proteine del latte, e il siero di latte, sono già riconosciuti come sicuri perché identiche alle proteine del latte che si ottengono da mucche, dice Datar, anche uno dei fondatori della società.
Il prodotto non può essere legalmente chiamato latte, però, perché la FDA ha standard di identità che definiscono specificamente il latte come le secrezioni lattea derivante da una mucca. “Questa definizione esclude completamente ogni tipo di bevanda prodotta dalla fermentazione o da altri strumenti della biologia molecolare”, dice Phillip Tong, ex direttore del Dairy Products Technology Center e professore emerito presso la California Polytechnic State University, San Luis Obispo. “Quando queste definizioni sono state promulgate, nessuno ha mai pensato che saremmo stati in grado di fare qualcosa del genere”, aggiunge.
La situazione normativa si complica con la carne delle cellule in coltura, in cui le cellule prelevate dal muscolo animale sono coltivate su impalcature speciali fino a formare filamenti di tessuto sufficiente (circa 20.000) per fare una polpetta o hamburger. In questo caso non è del tutto animale, e non si tratta esattamente un additivo alimentare, inteso come cibo.
“E 'un territorio inesplorato”, dice Nicole Negowetti, direttore per la politica del Good Food Institute, in Washington DC, senza scopo di lucro che supporta le alternative alimentari coltivate e di vegetali. Ad esempio, “da quello che posso affermare, i regolamenti USDA si basano su cibo da macellazione degli animali” dice.
Anche se i sostenitori dell'agricoltura cellulare tendono a soffermarsi sul processo perché dicono che potrebbe portare a prodotti più sicuri per gli esseri umani e ad una catena alimentare più sostenibile, la produzione-FDA guarda solo al prodotto finale. Quindi, se il prodotto finale è geneticamente modificato di mais, soia, o anche a base di carne, Negowetti dice che il prodotto dovrebbe essere regolata dalla FDA se è destinata ad essere un alimento.
Ma la carne da colture cellulari potrebbe anche rientrare sotto la supervisione FDA per la produzione di farmaci, osserva. Perché la FDA definisce un farmaco come qualcosa che comprende le cellule umane, tessuti ecc., potrebbe non essere così tanto una forzatura dire che il tessuto animale potrebbe essere incluso in questa definizione, anche, aggiunge.
Potrebbero essere disciplinati anche la carne delle cellule in coltura per la Nuova Animal Drug Application della FDA. Nell'ambito di questo regime, l'agenzia che regola farmaci somministrati agli animali o aggiunte al loro cibo. Quindi, se le aziende manipolano le culture di carne per migliorare il sapore, contenuti di grassi, o di altre qualità, potrebbe essere considerato alla stregua della somministrazione di un un farmaco ad un animale.
[email protected]
Per contribuire a fornire risposte, la Casa Bianca lo scorso anno ha lanciato un'iniziativa per rivedere e revisionare come le aziende degli Stati Uniti regolano biotecnologia agricola . E la National Academies of Sciences, Ingegneria, Medicina e di Washington, DC, sta lavorando ad un più ampio studio di futuri sviluppi delle biotecnologie e regolamentazione , con un rapporto previsto in uscita alla fine di quest'anno.
Nel frattempo, i leader del settore stanno pensando a come i loro potenziali alimenti di laboratorio potrebbero essere gestii dalle autorità di regolamentazione. Un approccio, pubblicato da Science Insider, è quello di mostrare che il loro prodotto è simile a un prodotto esistente che il test ha già dimostrato di utilizzare senza pericoli. “La maggior parte delle regolamentazioni alimentari stanno allineando i nuovi prodotti con qualcosa che è già riconosciuto come sicuro”, osserva Datar.
Questo è l'approccio già adottato dalle aziende che utilizzano microbi e altre biotecnologie per la produzione di enzimi e proteine che vengono aggiunti agli alimenti, fa notare Vincent Sewalt, senior director, gestione prodotti e normative, per la DuPont Industrial Biosciences, con sede a Palo Alto, California. Ad esempio, il lievito può essere utilizzato per la produzione di amilasi specifici, che sono enzimi per prodotti da forno per prolungare la freschezza. Tali additivi richiedono l'approvazione da parte della FDA prima dell'immissione sul mercato “a meno che non si riesce a dimostrare che sono sostanze generalmente riconosciute come sicure”, dice Sewalt. Per soddisfare questi standard noti nel settore come GRAS- le aziende iniziano selezionando ceppi microbici che sono noti per essere non tossici e non patogeni, quindi utilizzando quei ceppi per produrre i loro prodotti. “E questo può essere fatto in modo sicuro fino a quando si abbia selezionato un ceppo di sicurezza e ha dimostrato che la sicurezza attraverso ripetuti studi tossicologici”, conferma Sewalt.
Questa strategia potrebbe funzionare anche per le aziende che sperimentano l'utilizzo di lieviti ingegnerizzati per produrre singole proteine per creare i bianchi d'uovo, senza screpolature. In questo caso, le proteine del bianco d'uovo sono già considerati un ingrediente GRAS.
Lo stesso scenario potrebbe anche funzionare per Perfect Day, la startup che sta usando il lievito per fare proteine del latte, e quindi l'aggiunta di altri ingredienti per creare un latte senza l'utilizzo di bovini. Quelle proteine del latte, e il siero di latte, sono già riconosciuti come sicuri perché identiche alle proteine del latte che si ottengono da mucche, dice Datar, anche uno dei fondatori della società.
Il prodotto non può essere legalmente chiamato latte, però, perché la FDA ha standard di identità che definiscono specificamente il latte come le secrezioni lattea derivante da una mucca. “Questa definizione esclude completamente ogni tipo di bevanda prodotta dalla fermentazione o da altri strumenti della biologia molecolare”, dice Phillip Tong, ex direttore del Dairy Products Technology Center e professore emerito presso la California Polytechnic State University, San Luis Obispo. “Quando queste definizioni sono state promulgate, nessuno ha mai pensato che saremmo stati in grado di fare qualcosa del genere”, aggiunge.
La situazione normativa si complica con la carne delle cellule in coltura, in cui le cellule prelevate dal muscolo animale sono coltivate su impalcature speciali fino a formare filamenti di tessuto sufficiente (circa 20.000) per fare una polpetta o hamburger. In questo caso non è del tutto animale, e non si tratta esattamente un additivo alimentare, inteso come cibo.
“E 'un territorio inesplorato”, dice Nicole Negowetti, direttore per la politica del Good Food Institute, in Washington DC, senza scopo di lucro che supporta le alternative alimentari coltivate e di vegetali. Ad esempio, “da quello che posso affermare, i regolamenti USDA si basano su cibo da macellazione degli animali” dice.
Anche se i sostenitori dell'agricoltura cellulare tendono a soffermarsi sul processo perché dicono che potrebbe portare a prodotti più sicuri per gli esseri umani e ad una catena alimentare più sostenibile, la produzione-FDA guarda solo al prodotto finale. Quindi, se il prodotto finale è geneticamente modificato di mais, soia, o anche a base di carne, Negowetti dice che il prodotto dovrebbe essere regolata dalla FDA se è destinata ad essere un alimento.
Ma la carne da colture cellulari potrebbe anche rientrare sotto la supervisione FDA per la produzione di farmaci, osserva. Perché la FDA definisce un farmaco come qualcosa che comprende le cellule umane, tessuti ecc., potrebbe non essere così tanto una forzatura dire che il tessuto animale potrebbe essere incluso in questa definizione, anche, aggiunge.
Potrebbero essere disciplinati anche la carne delle cellule in coltura per la Nuova Animal Drug Application della FDA. Nell'ambito di questo regime, l'agenzia che regola farmaci somministrati agli animali o aggiunte al loro cibo. Quindi, se le aziende manipolano le culture di carne per migliorare il sapore, contenuti di grassi, o di altre qualità, potrebbe essere considerato alla stregua della somministrazione di un un farmaco ad un animale.
[email protected]
 Per contribuire a fornire risposte, la Casa Bianca lo scorso anno ha lanciato un'iniziativa per rivedere e revisionare come le aziende degli Stati Uniti regolano biotecnologia agricola . E la National Academies of Sciences, Ingegneria, Medicina e di Washington, DC, sta lavorando ad un più ampio studio di futuri sviluppi delle biotecnologie e regolamentazione , con un rapporto previsto in uscita alla fine di quest'anno.
Nel frattempo, i leader del settore stanno pensando a come i loro potenziali alimenti di laboratorio potrebbero essere gestii dalle autorità di regolamentazione. Un approccio, pubblicato da Science Insider, è quello di mostrare che il loro prodotto è simile a un prodotto esistente che il test ha già dimostrato di utilizzare senza pericoli. “La maggior parte delle regolamentazioni alimentari stanno allineando i nuovi prodotti con qualcosa che è già riconosciuto come sicuro”, osserva Datar.
Questo è l'approccio già adottato dalle aziende che utilizzano microbi e altre biotecnologie per la produzione di enzimi e proteine che vengono aggiunti agli alimenti, fa notare Vincent Sewalt, senior director, gestione prodotti e normative, per la DuPont Industrial Biosciences, con sede a Palo Alto, California. Ad esempio, il lievito può essere utilizzato per la produzione di amilasi specifici, che sono enzimi per prodotti da forno per prolungare la freschezza. Tali additivi richiedono l'approvazione da parte della FDA prima dell'immissione sul mercato “a meno che non si riesce a dimostrare che sono sostanze generalmente riconosciute come sicure”, dice Sewalt. Per soddisfare questi standard noti nel settore come GRAS- le aziende iniziano selezionando ceppi microbici che sono noti per essere non tossici e non patogeni, quindi utilizzando quei ceppi per produrre i loro prodotti. “E questo può essere fatto in modo sicuro fino a quando si abbia selezionato un ceppo di sicurezza e ha dimostrato che la sicurezza attraverso ripetuti studi tossicologici”, conferma Sewalt.
Questa strategia potrebbe funzionare anche per le aziende che sperimentano l'utilizzo di lieviti ingegnerizzati per produrre singole proteine per creare i bianchi d'uovo, senza screpolature. In questo caso, le proteine del bianco d'uovo sono già considerati un ingrediente GRAS.
Lo stesso scenario potrebbe anche funzionare per Perfect Day, la startup che sta usando il lievito per fare proteine del latte, e quindi l'aggiunta di altri ingredienti per creare un latte senza l'utilizzo di bovini. Quelle proteine del latte, e il siero di latte, sono già riconosciuti come sicuri perché identiche alle proteine del latte che si ottengono da mucche, dice Datar, anche uno dei fondatori della società.
Il prodotto non può essere legalmente chiamato latte, però, perché la FDA ha standard di identità che definiscono specificamente il latte come le secrezioni lattea derivante da una mucca. “Questa definizione esclude completamente ogni tipo di bevanda prodotta dalla fermentazione o da altri strumenti della biologia molecolare”, dice Phillip Tong, ex direttore del Dairy Products Technology Center e professore emerito presso la California Polytechnic State University, San Luis Obispo. “Quando queste definizioni sono state promulgate, nessuno ha mai pensato che saremmo stati in grado di fare qualcosa del genere”, aggiunge.
La situazione normativa si complica con la carne delle cellule in coltura, in cui le cellule prelevate dal muscolo animale sono coltivate su impalcature speciali fino a formare filamenti di tessuto sufficiente (circa 20.000) per fare una polpetta o hamburger. In questo caso non è del tutto animale, e non si tratta esattamente un additivo alimentare, inteso come cibo.
“E 'un territorio inesplorato”, dice Nicole Negowetti, direttore per la politica del Good Food Institute, in Washington DC, senza scopo di lucro che supporta le alternative alimentari coltivate e di vegetali. Ad esempio, “da quello che posso affermare, i regolamenti USDA si basano su cibo da macellazione degli animali” dice.
Anche se i sostenitori dell'agricoltura cellulare tendono a soffermarsi sul processo perché dicono che potrebbe portare a prodotti più sicuri per gli esseri umani e ad una catena alimentare più sostenibile, la produzione-FDA guarda solo al prodotto finale. Quindi, se il prodotto finale è geneticamente modificato di mais, soia, o anche a base di carne, Negowetti dice che il prodotto dovrebbe essere regolata dalla FDA se è destinata ad essere un alimento.
Ma la carne da colture cellulari potrebbe anche rientrare sotto la supervisione FDA per la produzione di farmaci, osserva. Perché la FDA definisce un farmaco come qualcosa che comprende le cellule umane, tessuti ecc., potrebbe non essere così tanto una forzatura dire che il tessuto animale potrebbe essere incluso in questa definizione, anche, aggiunge.
Potrebbero essere disciplinati anche la carne delle cellule in coltura per la Nuova Animal Drug Application della FDA. Nell'ambito di questo regime, l'agenzia che regola farmaci somministrati agli animali o aggiunte al loro cibo. Quindi, se le aziende manipolano le culture di carne per migliorare il sapore, contenuti di grassi, o di altre qualità, potrebbe essere considerato alla stregua della somministrazione di un un farmaco ad un animale.
[email protected]
Per contribuire a fornire risposte, la Casa Bianca lo scorso anno ha lanciato un'iniziativa per rivedere e revisionare come le aziende degli Stati Uniti regolano biotecnologia agricola . E la National Academies of Sciences, Ingegneria, Medicina e di Washington, DC, sta lavorando ad un più ampio studio di futuri sviluppi delle biotecnologie e regolamentazione , con un rapporto previsto in uscita alla fine di quest'anno.
Nel frattempo, i leader del settore stanno pensando a come i loro potenziali alimenti di laboratorio potrebbero essere gestii dalle autorità di regolamentazione. Un approccio, pubblicato da Science Insider, è quello di mostrare che il loro prodotto è simile a un prodotto esistente che il test ha già dimostrato di utilizzare senza pericoli. “La maggior parte delle regolamentazioni alimentari stanno allineando i nuovi prodotti con qualcosa che è già riconosciuto come sicuro”, osserva Datar.
Questo è l'approccio già adottato dalle aziende che utilizzano microbi e altre biotecnologie per la produzione di enzimi e proteine che vengono aggiunti agli alimenti, fa notare Vincent Sewalt, senior director, gestione prodotti e normative, per la DuPont Industrial Biosciences, con sede a Palo Alto, California. Ad esempio, il lievito può essere utilizzato per la produzione di amilasi specifici, che sono enzimi per prodotti da forno per prolungare la freschezza. Tali additivi richiedono l'approvazione da parte della FDA prima dell'immissione sul mercato “a meno che non si riesce a dimostrare che sono sostanze generalmente riconosciute come sicure”, dice Sewalt. Per soddisfare questi standard noti nel settore come GRAS- le aziende iniziano selezionando ceppi microbici che sono noti per essere non tossici e non patogeni, quindi utilizzando quei ceppi per produrre i loro prodotti. “E questo può essere fatto in modo sicuro fino a quando si abbia selezionato un ceppo di sicurezza e ha dimostrato che la sicurezza attraverso ripetuti studi tossicologici”, conferma Sewalt.
Questa strategia potrebbe funzionare anche per le aziende che sperimentano l'utilizzo di lieviti ingegnerizzati per produrre singole proteine per creare i bianchi d'uovo, senza screpolature. In questo caso, le proteine del bianco d'uovo sono già considerati un ingrediente GRAS.
Lo stesso scenario potrebbe anche funzionare per Perfect Day, la startup che sta usando il lievito per fare proteine del latte, e quindi l'aggiunta di altri ingredienti per creare un latte senza l'utilizzo di bovini. Quelle proteine del latte, e il siero di latte, sono già riconosciuti come sicuri perché identiche alle proteine del latte che si ottengono da mucche, dice Datar, anche uno dei fondatori della società.
Il prodotto non può essere legalmente chiamato latte, però, perché la FDA ha standard di identità che definiscono specificamente il latte come le secrezioni lattea derivante da una mucca. “Questa definizione esclude completamente ogni tipo di bevanda prodotta dalla fermentazione o da altri strumenti della biologia molecolare”, dice Phillip Tong, ex direttore del Dairy Products Technology Center e professore emerito presso la California Polytechnic State University, San Luis Obispo. “Quando queste definizioni sono state promulgate, nessuno ha mai pensato che saremmo stati in grado di fare qualcosa del genere”, aggiunge.
La situazione normativa si complica con la carne delle cellule in coltura, in cui le cellule prelevate dal muscolo animale sono coltivate su impalcature speciali fino a formare filamenti di tessuto sufficiente (circa 20.000) per fare una polpetta o hamburger. In questo caso non è del tutto animale, e non si tratta esattamente un additivo alimentare, inteso come cibo.
“E 'un territorio inesplorato”, dice Nicole Negowetti, direttore per la politica del Good Food Institute, in Washington DC, senza scopo di lucro che supporta le alternative alimentari coltivate e di vegetali. Ad esempio, “da quello che posso affermare, i regolamenti USDA si basano su cibo da macellazione degli animali” dice.
Anche se i sostenitori dell'agricoltura cellulare tendono a soffermarsi sul processo perché dicono che potrebbe portare a prodotti più sicuri per gli esseri umani e ad una catena alimentare più sostenibile, la produzione-FDA guarda solo al prodotto finale. Quindi, se il prodotto finale è geneticamente modificato di mais, soia, o anche a base di carne, Negowetti dice che il prodotto dovrebbe essere regolata dalla FDA se è destinata ad essere un alimento.
Ma la carne da colture cellulari potrebbe anche rientrare sotto la supervisione FDA per la produzione di farmaci, osserva. Perché la FDA definisce un farmaco come qualcosa che comprende le cellule umane, tessuti ecc., potrebbe non essere così tanto una forzatura dire che il tessuto animale potrebbe essere incluso in questa definizione, anche, aggiunge.
Potrebbero essere disciplinati anche la carne delle cellule in coltura per la Nuova Animal Drug Application della FDA. Nell'ambito di questo regime, l'agenzia che regola farmaci somministrati agli animali o aggiunte al loro cibo. Quindi, se le aziende manipolano le culture di carne per migliorare il sapore, contenuti di grassi, o di altre qualità, potrebbe essere considerato alla stregua della somministrazione di un un farmaco ad un animale.
[email protected]
Articolo Precedente
Jamie Snider partorisce due gemelli ma non sconfigge il cancro per la terza volta
Articolo Successivo
Bambini e ossa più fragili, colpa dell’inattività



